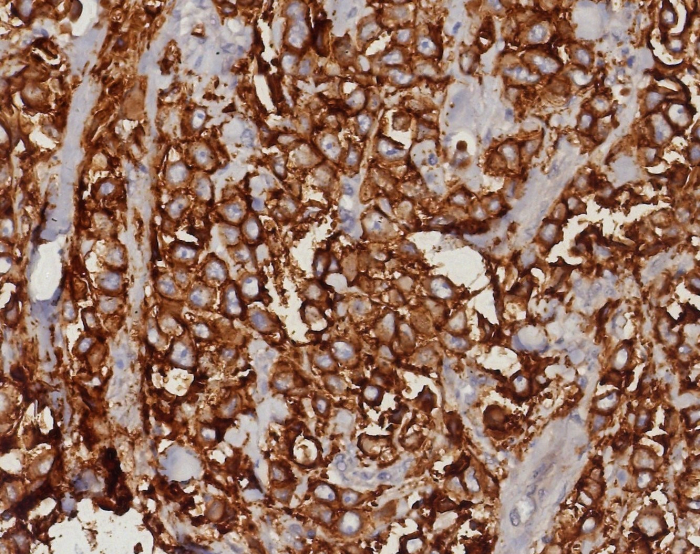
EpCAM/TROP1 Antibody (EGP40/8191R) - Azide and BSA Free

EpCAM/TROP1 Antibody (EGP40/8191R) - Azide and BSA Free
Novus Biologicals, part of Bio-Techne | Catalog # NBP3-21072
Recombinant Monoclonal Antibody


Conjugate
Catalog #
Key Product Details
Species Reactivity
Human
Applications
Immunohistochemistry-Paraffin
Label
Unconjugated
Antibody Source
Recombinant Monoclonal Rabbit IgG Kappa Clone # EGP40/8191R
Format
Azide and BSA Free
Concentration
1 mg/ml
Product Specifications
Immunogen
Recombinant human EpCAM/TROP1 fragment from extracellular domain (around aa100-224) (exact sequence is proprietary)
Localization
Cell surface
Specificity
Antibody to Ep-CAM has been used to distinguish adenocarcinoma from pleural mesothelioma and hepatocellular carcinoma This antibody is also useful in distinguishing serous carcinomas of the ovary from mesothelioma
Clonality
Monoclonal
Host
Rabbit
Isotype
IgG Kappa
Description
Positive Controls: Human breast tumor.
Antibody with azide - store at 2 to 8C. Antibody without azide - store at -20 to -80C. Non-hazardous. No MSDS required.
Antibody with azide - store at 2 to 8C. Antibody without azide - store at -20 to -80C. Non-hazardous. No MSDS required.
Scientific Data Images for EpCAM/TROP1 Antibody (EGP40/8191R) - Azide and BSA Free
EpCAM/TROP1 Antibody (EGP40/8191R)
IHC analysis of formalin-fixed, paraffin-embedded human prostate carcinoma. EpCAM/TROP1 antibody (EGP40/8191R). Inset: PBS instead of primary antibody; secondary only negative control.EpCAM/TROP1 Antibody (EGP40/8191R)
IHC analysis of formalin-fixed, paraffin-embedded human bladder.EpCAM/TROP1 antibody (EGP40/8191R). HIER: Tris/EDTA, pH9.0, 45min. Secondary: HRP-polymer, 30min. DAB, 5min.EpCAM/TROP1 Antibody (EGP40/8191R)
IHC analysis of formalin-fixed, paraffin-embedded human tonsil. Negative tissue control using EpCAM/TROP1 antibody (EGP40/8191R) at 2ug/ml in PBS for 30min RT. HIER: Tris/EDTA, pH9.0, 45min. Secondary: HRP-polymer, 30min. DAB, 5min.Applications for EpCAM/TROP1 Antibody (EGP40/8191R) - Azide and BSA Free
Application
Recommended Usage
Immunohistochemistry-Paraffin
1-2 ug/ml
Application Notes
Immunohistochemistry (Formalin-fixed): 1-2ug/ml for 30 minutes. at RT. Staining of formalin-fixed tissues requires heating tissue sections in 10mM Tris with 1mM EDTA, pH 9.0, for 45 min at 95C followed by cooling at RT for 20 minutes.
Optimal dilution for a specific application should be determined.
Optimal dilution for a specific application should be determined.
Formulation, Preparation, and Storage
Purification
Protein A purified
Formulation
10mM PBS
Format
Azide and BSA Free
Preservative
No Preservative
Concentration
1 mg/ml
Shipping
The product is shipped with polar packs. Upon receipt, store it immediately at the temperature recommended below.
Stability & Storage
Store at -20 to -70C. Avoid freeze-thaw cycles.
Background: EpCAM/TROP1
EpCAM functions as an intracellular signaling molecule and contributes to regulation of epithelial-to-mesenchymal (EMT) transition (4,5). EpCAM is cleaved during the process of regulated intramembrane proteolysis (RIP) (4,5). Initial cleavage occurs at the membrane via a disintegrin and metalloprotease 17 (ADAM17) which releases EpCAM's extracellular domain (EpEx) (4,5). A secondary cleavage is mediated by presenilin 2 (PSEN2) which releases EpCAM's cytoplasmic trail (EpICD) (4,5). EpICD translocates to the nucleus where it associates with beta-catenin, FHL-2, and LEF-1 and induces transcription of genes related to EMT and tumor growth (4,5). EpCAM has also been shown to regulate structure and functionality of the apical junction complex of cells through direct interaction with claudin-7 and association with E-cadherin (2,5). Loss of EpCAM disrupts adherins junction and tight junction structure and function (2).
References
1. Mohtar MA, Syafruddin SE, Nasir SN, Low TY. Revisiting the Roles of Pro-Metastatic EpCAM in Cancer. Biomolecules. 2020; 10(2):255. https://doi.org/10.3390/biom10020255
2. Huang L, Yang Y, Yang F, et al. Functions of EpCAM in physiological processes and diseases (Review). Int J Mol Med. 2018; 42(4):1771-1785. https://doi.org/10.3892/ijmm.2018.3764
3. Brown TC, Sankpal NV, Gillanders WE. Functional Implications of the Dynamic Regulation of EpCAM during Epithelial-to-Mesenchymal Transition. Biomolecules. 2021; 11(7):956. https://doi.org/10.3390/biom11070956
4. Uniprot (P16422)
5. Schnell U, Cirulli V, Giepmans BN. EpCAM: structure and function in health and disease. Biochim Biophys Acta. 2013; 1828(8):1989-2001. https://doi.org/10.1016/j.bbamem.2013.04.018
Long Name
Epithelial Cell Adhesion Molecule
Alternate Names
17-1A, CD326, GA733-2, gp40, KS1/4, M4S1, TACSTD1, TROP1
Gene Symbol
EPCAM
Additional EpCAM/TROP1 Products
Product Documents for EpCAM/TROP1 Antibody (EGP40/8191R) - Azide and BSA Free
Product Specific Notices for EpCAM/TROP1 Antibody (EGP40/8191R) - Azide and BSA Free
This product is for research use only and is not approved for use in humans or in clinical diagnosis. Primary Antibodies are guaranteed for 1 year from date of receipt.
Loading...
Loading...
Loading...
Loading...
Loading...